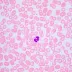

Mikroskop MAGUS Bio 240T (40-1000x) je moderní biologický mikroskop s výjimečnými vlastnostmi, ideální pro vzdělávání, výzkum a laboratorní práci. Tento kompaktní a výkonný model umožňuje práci s průhlednými a průsvitnými biologickými vzorky metodou jasného pole.
Klíčovou vlastností mikroskopu je trinokulární hlava s možností montáže digitální videokamery a kódovaný revolverový nosič, který udržuje nastavenou intenzitu světla při změně objektivů. Přehledný LCD displej zobrazuje provozní parametry jako je zvětšení, intenzita osvětlení a provozní režim. Optika s korekcí na nekonečno poskytuje ostrý a kvalitní obraz i při vysokém zvětšení.
Mikroskop je vybaven:
-
Souosými knoflíky pro hrubé a jemné zaostřování pro maximální pohodlí při práci,
-
Mechanickým stolkem s jemným pohybem díky řemenovému pohonu,
-
Pevně nastaveným Abbeho kondenzorem s numerickou aperturou 1,25, zajišťujícím konzistentní kvalitu obrazu,
-
3W LED osvětlením s nastavitelnou teplotou barev od 3000K do 7000K.
Mezi další výhody patří automatické přizpůsobení jasu při výměně objektivů a praktický režim spánku, který šetří energii. Díky ergonomickému designu s ukrytým napájecím adaptérem a bočními madly je mikroskop pohodlný i při časté manipulaci.
Mikroskop MAGUS Bio 240T je skvělou volbou pro zkušené uživatele, kteří požadují vysokou kvalitu obrazu, snadné ovládání a profesionální výkon v každodenním laboratorním prostředí.
Obsah balení:
-
Stojan se zdrojem procházejícího světla, zaostřovacím mechanismem, pracovním stolkem, držákem kondenzoru a revolverovým nosičem objektivů
-
Abbeho kondenzor
-
Trinokulární hlava
-
Rovinný achromatický objektiv s korekcí na nekonečno: 4x/0,10
-
Rovinný achromatický objektiv s korekcí na nekonečno: 10x/0,25
-
Rovinný achromatický objektiv s korekcí na nekonečno: 40x/0,65 (odpružený)
-
Rovinný achromatický objektiv s korekcí na nekonečno: 100x/1,25 olej (odpružený)
-
Okuláry 10x/20 mm s dlouhým očním reliéfem (2 ks)
-
Očnice okuláru (2 ks)
-
Adaptér pro fotoaparát (C-mount)
-
Světelný filtr
-
Nádobka s imerzním olejem
-
Napájecí adaptér a napájecí kabel
-
Protiprachová krytka
-
Uživatelská příručka a záruční list
Volitelné příslušenství (k dispozici na přání): digitální fotoaparát, kalibrační sklíčko, monitor.

Převodem
Na fakturu
Dobírka
Převodem
Na fakturu
Dobírka